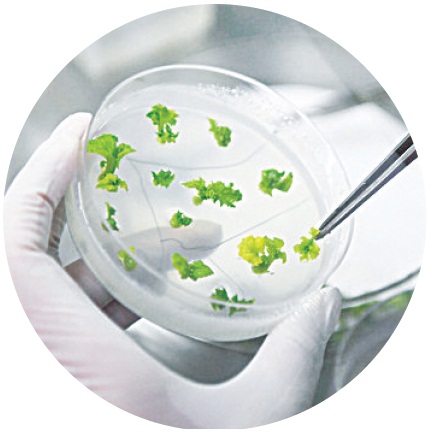

农业芯片,自主可控筑基石
农民日报·中国农网记者 杨梦帆 2024年3月7日

加快推进种业振兴行动
完善联合研发和应用协作机制
加大种源关键核心技术攻关
加快选育推广生产急需的自主优良品种
开展重大品种研发推广应用一体化试点
推动生物育种产业化扩面提速
作物良种覆盖率超过96%,品种对单产贡献率达45%
畜禽、水产核心种源自给率分别超过75%和85%
新收集种质资源53万份,初步摸清资源家底
国产白羽肉鸡品种市场占有率提高10个百分点、超过25%
健全216个作物制种基地县
300个种畜禽场站
91个水产原良种场组成的良种繁育“国家队”
··········
海南三亚南繁硅谷,崖州湾国家实验室,各实验团队“揭榜挂帅”,领军科学家和年轻的育种人昼夜奋战,致力于种业科研创新……
北京平谷农业中关村,科研单位和育种企业各扬所长,高油高产大豆品种培育攻关正酣……
广东湛江,国家863计划项目海水养殖种子工程南方基地,一组南美白对虾新品种,正在“打针”进行抗病性状测试肌肉注射实验……
非洲坦桑尼亚,我国自主培育的高产蛋种鸡“京红1号”,于2023年10月产下第一枚鸡蛋……
农稳社稷,种子为基!种子这个农业“芯片”,关系国家粮食安全,关乎农业效益和农民收入,关涉农产品全球竞争力,是发展新质生产力的重要领域。内蕴着新质生产力的特征,落实习近平总书记对抓住种子这个“要害”的要求,我国于2021年起实施种业振兴行动,明确“一年开好头、三年打基础、五年见成效、十年实现重大突破”总体安排,推进种质资源保护、创新攻关、企业扶优、基地提升、市场净化五项行动,蹄疾步稳,成效斐然!
发展种业领域新质生产力方向明确,种业振兴三年基础已打好,下一步,怎样尽快实现关键新品种攻关突破?怎样培育一批堪当新主体重任的种子企业?如何为种业高质量发展营造更好的新环境?全国两会期间,记者就此话题采访了多位代表委员。
种质资源增基数,品种创新求突破
种质资源是一个国家的关键性战略资源,哪个国家占有的种质资源越丰富,哪个国家的育种开发潜力就越大。
作为种业振兴行动的“第一仗”,2021-2023年,我国用3年时间完成了第三次全国农业种质资源普查与收集,摸清了种质资源家底,共新收集农作物资源13.9万份、畜禽资源27万份、水产资源12万份,而且抢救性保护了一批濒危珍稀资源,实现应收尽收、应保尽保。
“资源收集,遍布天山南北。”全国政协委员、农业农村部植物新品种测试(乌鲁木齐)分中心副主任王威告诉记者,自种质资源普查与收集行动启动以来,新疆采集移交了6万多条数据,分14批次向国家农作物种质资源库(圃)移交了全部种质资源,其中还有一批像且末香蒜、橡胶草这样的珍稀特色资源,为种业振兴作出了新疆贡献。
这些宝贵的种质资源存放在各地现代化的种质资源库中,通过先进技术低温、干燥保存,确保种质资源的多样性和持久性。国家级种质资源库,作为种业领域的“国之重器”,承担着为种业创新夯基筑石的战略性使命。
收集和保存不是最终目标。“这一次收集到了一批珍稀的种质资源,也抢救了不少濒危的种质资源。”全国政协委员、甘肃省农业科学院原院长马忠明表示,种质资源收集好后,关键是进一步做好种质资源的鉴定评价和创新利用工作。
“优良品种的育成离不开种质资源的收集保存,但还要挖掘、利用育种创新。”王威表示,只有掌握海量的种质资源,才会有源源不断的素材去挖掘,也只有用到品种创新中去,这些才真正称得上“资源”。
种业振兴,关键在品种,尤其是当家品种,更要牢牢攥在自己手里。2022年,作为我国首批审定入市的国产白羽肉鸡新品种之一,“圣泽901”的持续选育改良,标志着我国白羽肉鸡打破了种源长期依赖进口局面后,再次取得质的突破;2023年,短生育期油菜新品种“中油早1号”创造了三熟制模式下短生育期油菜高产纪录,为破解南方冬闲田三熟制生产瓶颈提供了突破性品种支撑……
一系列优质品种的培育、推广应用,有力地支撑了农业高质量发展,还有一些更令人期待的关键“卡脖子”品种,则正在紧锣密鼓地培育中。
“2022年大豆丰产了,但是本应该丰收的农民却因为大豆价格下行并未获得更多收益。”在全国人大代表,九三集团铁岭大豆科技有限公司党委书记、总经理史洪斌看来,“丰产不丰收”的原因有很多,其中一个方面就是豆农所种的,不是豆企所需的。大豆加工企业一般需要大豆原料榨油和豆粕,这就需要高油大豆品种,而我国高油高产大豆品种与国际水平相比还有一定差距。
近两三年,中央一号文件连续部署扩种大豆和油料作物,“实施‘北豆南移’战略,在华南地区扩种大豆,可以有效缓解我国大豆供需矛盾。”全国人大代表、华南农业大学科学研究院院长谢青梅今年带上全国两会的建议是《推进实施“北豆南移”国家战略,提升我国大豆自给率》。谢青梅认为,“北豆南移”需要整体规划、全链设计,其中第一个环节就是品种,要聚焦热带亚热带大豆资源搜集和精准鉴定、大豆超高产性状形成的分子机制研究、高油高产多抗兼广适应性大豆新品种选育等方面努力实现攻关突破,她还建议设立“北豆南移与南豆北移的广适应性超高产品种选育”重大核心攻关项目,充分利用和解析热带品种的优势性状,通过常规育种和生物育种进行南北资源基因整合,加快培育适合不同地区的超高产突破性品种。

科研机构夯基础,种业企业促转化
企业是技术创新的主体,也是发展现代种业的骨干力量,是否拥有一批具备集成创新能力、适应市场需求的种业龙头企业,一定程度上决定了种业领域新质生产力水平。目前,我国国家种业振兴企业阵型已初步构建,69家农作物、86家畜禽、121家水产优势企业,形成了种业振兴骨干力量。
“作为中央企业,国投集团将牵头做好生物产业相关工作,以生物育种技术为突破口,实现种业科技高水平自立自强,通过科技-产业-金融协同创新,引导种业产业快速发展,保障国家粮食安全。”全国政协委员,国投集团党组书记、董事长付刚峰表示。
种企发展怎么干、种企合作怎么搞?“种业发展处在一个非常好的机遇期,科研单位和种业企业联合可以更好地促进种业高质量发展。”王威建议,科研单位和种企也要各有分工、各有侧重。科研单位要将更多精力投入到基础理论和育种技术的研究,在种质资源挖掘利用上多下功夫。企业天然了解市场,创新力活跃,应该多在培育上做文章,现在已经有了很好的环境、政策和法治保障,科企合作可以大大加快种业振兴步伐。
实现种源自主可控,必须夯实优势种业企业这个供种“基本盘”。
“健全产学研联合育种机制,加快牛羊专门化品种选育,逐步提高核心种源自给率。”全国政协委员、延边畜牧开发集团有限公司董事长吕爱辉认为,企业一方面对好的品种有需求,另一方面在技术、人才方面存在局限性,可以与研究相关领域的科研单位、院校合作,弥补企业在研发方面的短板。
“企业在新品种选育这方面存在一些短板,但是转化是它的长项,就要发挥它的优势。”马忠明建议,企业应该跟科研单位建立一个联合体,发挥各自的长处,建立合理体制机制,实现共赢。
在国家一系列好政策带动下,种企国际影响力逐渐提高。2022年,我国农作物种子出口额达2.6亿美元,比2020年增长10%。“走出去”,开拓全球市场也是必由之路。
全国政协委员,民进中央常委、宁夏区委会主委王春秀建议,提升种企综合国际竞争力,需要相关行业部门聚焦国际种业市场发展,加强对我国种业“走出去”的布局研究,进一步深化我国种业企业进军国际市场的行业规划,为种企“走出去”提供政策指引。同时,应当鼓励有条件的制种企业在境外建设种子基地,一方面更好地为境外客户提供便利服务,带动“一带一路”沿线国家经济发展,并提升我国种企影响力。
综合平台为支撑,法律护航作保障
海南三亚独特的光热条件,让三亚成为育种的“加速器”。2030年这里将建成集科研、生产、销售、科技交流、成果转化于一体的服务全国的南繁硅谷。
像南繁硅谷这样综合平台的建设,也让马忠明羡慕不已。“它是一个相对完整的创新体系平台,我们是可以借鉴的,而且今年的中央一号文件也支持重大创新平台建设。”马忠明说,甘肃河西走廊作为全国现代种业三大核心基地之一,是我国玉米种业发展的战略要地,对确保国家粮食安全发挥了重要的作用。
马忠明建议,在张掖成立国家玉米种业区域创新中心,统筹国内外科研院校和企业的相关资源,集中力量解决关键技术与产品,加大创新能力争取在生物育种技术、艺机一体化、信息化等关键技术及装备方面取得重大突破。
种业安全同样需要法律护航。2022年3月,新的《种子法》开始施行,这是《种子法》第四次修订,强调要把种源安全提升到关系国家安全的战略高度,要综合运用法律、经济、技术、行政等多种手段,解决影响我国种业发展的假冒伪劣、套牌侵权等突出问题。
这次修订明确以强化种业知识产权保护为重点,建立实质性派生品种制度,扩大植物新品种权的保护范围和保护环节,加大侵权赔偿力度,推动建立鼓励和支持育种原始创新的制度体系,对于促进种业高质量发展,筑牢粮食安全和现代农业发展基础具有重要意义。
“我从事品种测试工作,对《种子法》关注度高一些。”王威告诉记者,新修订的《种子法》开始实施实质性派生品种制度,这种制度是激励育种原始创新的国际通行做法,能够从源头上解决品种同质化严重问题,有助于强化种业知识产权保护,并构建公平公正的利益分享机制。“用中国种子保障中国粮食安全,促进种业高质量发展,对筑牢粮食安全和现代农业发展基础具有重要意义。”王威表示。
推动种业振兴走深走实
农民日报·中国农网记者 王艳
湖南省湘潭市农业农村局局长刘良丰:
推动种业振兴走深走实
农民日报·中国农网记者 王艳
加快推动高水平种业科技自立自强,引导资源要素向种业企业聚集,方能推进种业高质量发展。要落实“深入实施种业振兴行动”,应点面结合、多措并举,方能推动种业振兴见实效。
一是要用好载体。要做好种业资源保护,重点是要用好国家种质资源库和地方保种场等重要载体。尽可能用好地方保种场,推动种业资源原产地保种;二是要搭好桥梁。建立种业振兴政府、企业、科研机构沟通机制,把种业振兴推上更高维度。近年来,湖南省湘潭市开展育种攻关合作项目近10个,离不开岳麓山种业创新中心和院士工作站等平台充当桥梁纽带;三是要做好运用。种业振兴,资源利用是落脚点。随着湘潭种业研究成果的推广,地标农产品产业化成效显著,沙子岭猪产业链已达到10亿级别,湘莲产业链达到100亿级别;四是要管好市场。优化种业市场秩序,依托农业综合行政执法改革成果,推动行业监管与执法有效衔接,为种业安全提供保障。
甘肃省酒泉市肃州区现代种业管理办公室副主任朱健:
打造中国种业“北育硅谷”
农民日报·中国农网记者 鲁明
近年来,甘肃省酒泉市肃州区国家现代农业(种业)产业园深入贯彻种业振兴行动实施方案,围绕种业“卡脖子”技术和品种研发培育,重点支持关键种质优异基因挖掘、生物育种技术与核心种源攻关等,建成具备国家标准的分子育种、种子检验、病理检测、土肥检测的种子科研中心,与中国农科院、西北农林科技大学等12家院校建立合作平台,研发培育了“敦玉735”“敦玉810”等知名种子品种,审定或登记品种1000多个。
下一步,园区将立足自身独特优势,育种制种双向并重,规划建设种业科技创新中心和种业研发集群孵化中心;着眼对接种质创新、高产基因等国内先进生物育种技术,创新突破特种作物种源“卡脖子”难题;以商业化育种为导向,实现育种研发重大技术创新成果的推广应用;联动完善粮食、瓜菜等作物种业全品类前端研发和检验检测,打造中国种业“北育硅谷”和中国西部种业发展高地。
海南省南繁协会副会长王仕明:
推动水稻制种高质量发展
农民日报·中国农网记者 邓卫哲
育出好品种后,还需要生产出更多好种子,才能真正惠及广大农民。海南省不仅是国家种业创新的南繁硅谷,更是我国重要的杂交水稻南繁制种基地,每年制种面积约20万亩,生产的水稻种子可供3000万到4000万亩大田种植。
为了推动杂交水稻制种产业高质量发展,打造种业带动乡村振兴样板区。一是要推行水稻制种全程机械化。加大创新投入,研发适合制种田插秧、种子烘干精选的先进机械设备,组织定期的机械化种植培训,鼓励农民和企业采用全程机械化生产方式;二是利用好智能设备及大数据。建立精确的制种花期预测模型,为农民提供准确的花期调节建议。利用无人机、大数据分析等技术,实时监测作物生长情况及中长期气候变化分析。同时,建立数据共享平台,让农民、科研机构、企业等各方能够共享数据资源,共同推动种业生产智能化发展;三是要创新金融支持方式。试点农业(水稻制种)设施设备及配套用地的产权登记,为农民和企业提供清晰的产权证明。建立完善的风险保障机制,降低农民和企业的生产风险。
中国农业科学院农业经济与发展研究所周慧:
以前沿科技抢占制高点
农民日报·中国农网记者 李丽颖
对标发达国家涉农领域科技发展形势,当前我国农业科技原始创新仍然不足,总体处于“少数领跑、多数并跑和跟跑”格局。要创新农业科技体系,打破土地劳动力等资源束缚,坚持需求导向、科技匹配生产力,聚焦生物育种、农机装备、智慧农业等关键核心技术及农业强国建设目标任务,以前沿科技抢占全球创新和产业竞争制高点。
塑造新质生产力关键在人才的培养,充分研判未来农业发展对人才的知识、能力、素质需求,打造多元化多层次的人才队伍。聚集一批领军人才,打造一支战略科学家队伍,发挥高等学校学科人才优势,培养一批青年人才。鼓励成果转化,形成一批专业化的成果转化人才。加快产学研深度融合,瞄准现代化、智能化、绿色化等方向,以科学研究为基础、技术突破为核心、成果转化为目标,通过发展新质生产力,着力提高全要素生产率,推动先进技术、实用装备等尽快转化为现实生产力。
河南省小麦产业技术体系首席专家雷振生:
加快种业科技成果转化
农民日报·中国农网记者 王帅杰
种业要振兴,重大品种选育推广是关键。一方面要扎实推进种业基础研究,攻克育种关键核心技术,加快形成体系化的种业科技创新能力,围绕着种业“卡脖子”关键技术开展联合攻关。
另一方面,要聚焦重点领域关键品种,完善联合研发和推广应用协作机制,通过揭榜挂帅、专项攻关等,加快选育推广生产急需的自主优良品种,把当家品种牢牢攥在自己手中;加强产学研合作,鼓励支持企业与科研院所共同参与,突破农业科研与生产脱节瓶颈,应当建立科技资源共享机制、人才联合培养与交流机制,有效整合双方信息、技术、人才等科技创新资源。积极以“科研+基地+农户+企业”等多种科技成果转化模式,进行产业化推广,实现农业高质量发展。